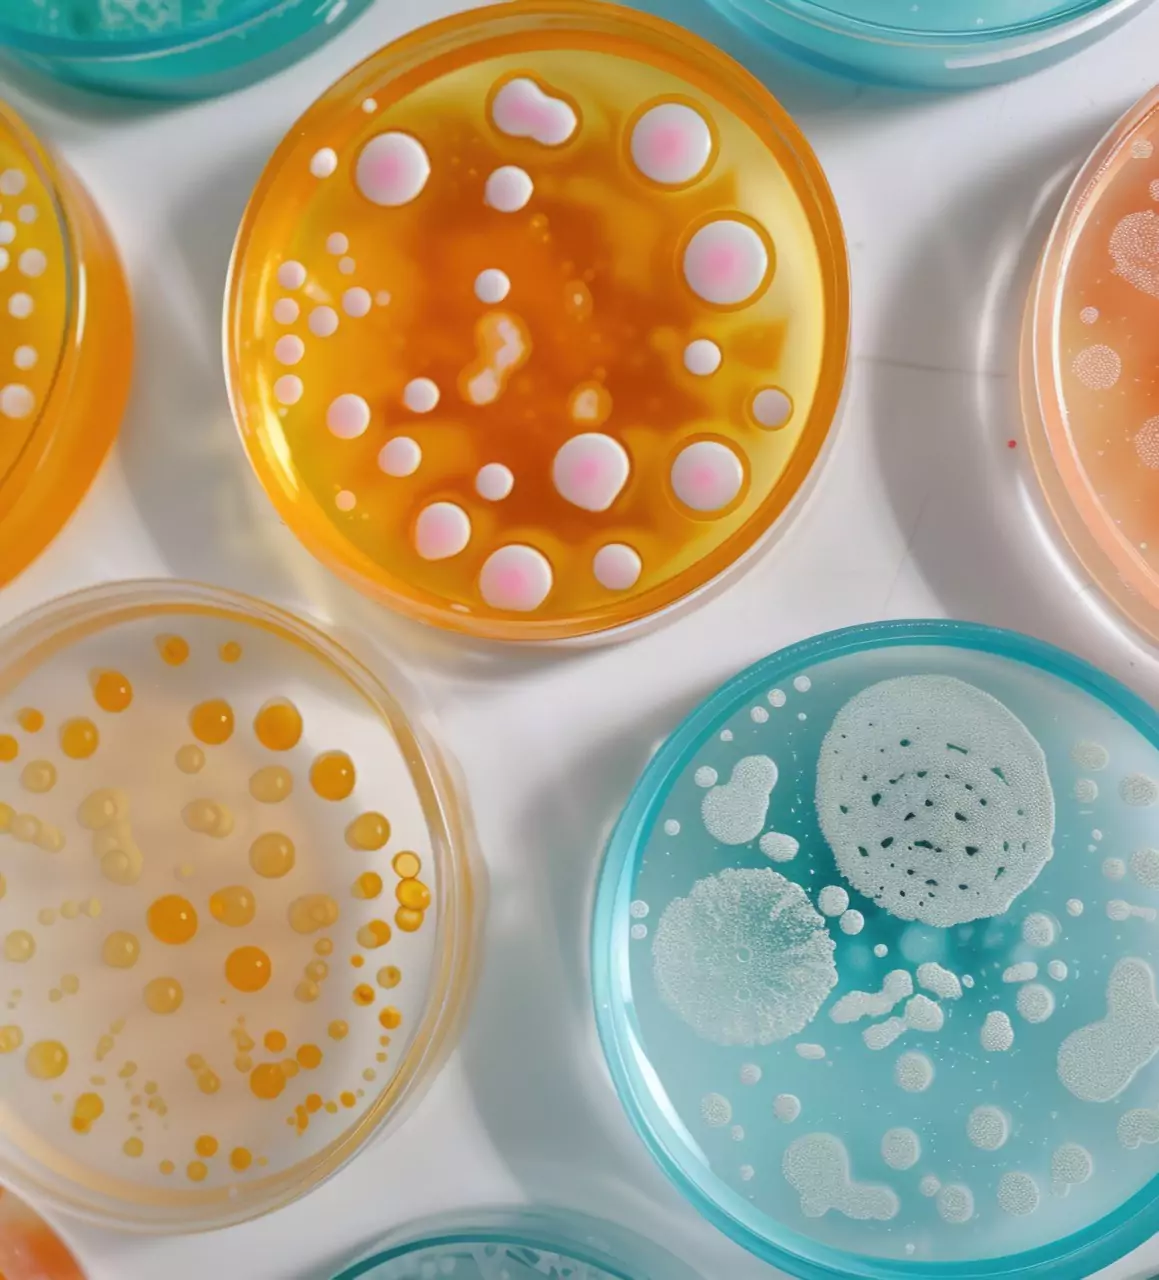

Services
Service Overview

There are several different methods of sampling for mold, including air sampling, surface sampling, and bulk sampling.

Once samples have been collected, they need to be analyzed in a laboratory to determine the presence and concentration of mold spores.


It’s important to interpret the results in the context of the specific situation and the potential health risks to occupants of the building.

We apply preventive treatments and perform final air quality tests to ensure a mold-free environment.


Service Overview
Satisfied Customer
Sarah L.
Satisfied Customer
James R.
Satisfied Customer
Monica T.

Contact Us
If you have any questions or problems simply use the following contact details.
or call us at:
or mail us at:
© 2025 Air Quality. All rights reserved.